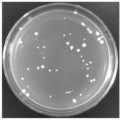

CN108728374B - A strain of S. adherens dt8 and its application in degrading paclobutrazol - Google Patents
A strain of S. adherens dt8 and its application in degrading paclobutrazolDownload PDFInfo
- Publication number
- CN108728374B CN108728374BCN201810434289.6ACN201810434289ACN108728374BCN 108728374 BCN108728374 BCN 108728374BCN 201810434289 ACN201810434289 ACN 201810434289ACN 108728374 BCN108728374 BCN 108728374B
- Authority
- CN
- China
- Prior art keywords
- paclobutrazol
- strain
- soil
- degrading
- growth
- Prior art date
- Legal status (The legal status is an assumption and is not a legal conclusion. Google has not performed a legal analysis and makes no representation as to the accuracy of the status listed.)
- Active
Links
- 239000005985PaclobutrazolSubstances0.000titleclaimsabstractdescription71
- RMOGWMIKYWRTKW-UONOGXRCSA-N(S,S)-paclobutrazolChemical compoundC([C@@H]([C@@H](O)C(C)(C)C)N1N=CN=C1)C1=CC=C(Cl)C=C1RMOGWMIKYWRTKW-UONOGXRCSA-N0.000titleclaimsabstractdescription70
- 230000000593degrading effectEffects0.000titleclaimsabstractdescription14
- 239000002689soilSubstances0.000claimsabstractdescription37
- 241001528536Ensifer adhaerensSpecies0.000claimsdescription31
- 230000001580bacterial effectEffects0.000claimsdescription11
- 238000000034methodMethods0.000claimsdescription8
- 239000010455vermiculiteSubstances0.000claimsdescription8
- 229910052902vermiculiteInorganic materials0.000claimsdescription8
- 238000000855fermentationMethods0.000claimsdescription7
- 230000004151fermentationEffects0.000claimsdescription7
- 235000019354vermiculiteNutrition0.000claimsdescription7
- 230000000813microbial effectEffects0.000claimsdescription4
- 244000005700microbiomeSpecies0.000claimsdescription4
- 239000003795chemical substances by applicationSubstances0.000claimsdescription3
- 238000002360preparation methodMethods0.000claimsdescription3
- 238000004321preservationMethods0.000claimsdescription3
- 239000002068microbial inoculumSubstances0.000claims4
- 241000233866FungiSpecies0.000claims2
- 241000224485PhysarumSpecies0.000claims1
- 230000012010growthEffects0.000abstractdescription27
- 230000000855fungicidal effectEffects0.000abstractdescription3
- 239000000417fungicideSubstances0.000abstractdescription3
- 230000002401inhibitory effectEffects0.000abstractdescription3
- 239000000126substanceSubstances0.000abstractdescription3
- 235000013305foodNutrition0.000abstractdescription2
- 230000004060metabolic processEffects0.000abstract1
- 239000002609mediumSubstances0.000description15
- 240000008790Musa x paradisiacaSpecies0.000description10
- PEDCQBHIVMGVHV-UHFFFAOYSA-NGlycerineChemical compoundOCC(O)COPEDCQBHIVMGVHV-UHFFFAOYSA-N0.000description9
- 230000000694effectsEffects0.000description9
- XLYOFNOQVPJJNP-UHFFFAOYSA-NwaterSubstancesOXLYOFNOQVPJJNP-UHFFFAOYSA-N0.000description9
- SRBFZHDQGSBBOR-IOVATXLUSA-ND-xylopyranoseChemical compoundO[C@@H]1COC(O)[C@H](O)[C@H]1OSRBFZHDQGSBBOR-IOVATXLUSA-N0.000description8
- 235000018290Musa x paradisiacaNutrition0.000description8
- FAPWRFPIFSIZLT-UHFFFAOYSA-MSodium chlorideChemical compound[Na+].[Cl-]FAPWRFPIFSIZLT-UHFFFAOYSA-M0.000description8
- 239000002054inoculumSubstances0.000description8
- 241000894006BacteriaSpecies0.000description7
- 241000196324EmbryophytaSpecies0.000description7
- 230000000877morphologic effectEffects0.000description7
- PYMYPHUHKUWMLA-UHFFFAOYSA-NarabinoseNatural productsOCC(O)C(O)C(O)C=OPYMYPHUHKUWMLA-UHFFFAOYSA-N0.000description6
- SRBFZHDQGSBBOR-UHFFFAOYSA-Nbeta-D-Pyranose-LyxoseNatural productsOC1COC(O)C(O)C1OSRBFZHDQGSBBOR-UHFFFAOYSA-N0.000description6
- 230000015556catabolic processEffects0.000description6
- 238000006731degradation reactionMethods0.000description6
- 229910017053inorganic saltInorganic materials0.000description6
- 239000007788liquidSubstances0.000description6
- 239000007787solidSubstances0.000description6
- 10802000446516S ribosomal RNAProteins0.000description5
- 241000209140TriticumSpecies0.000description5
- 235000021307TriticumNutrition0.000description5
- 239000000575pesticideSubstances0.000description5
- 239000000843powderSubstances0.000description5
- 229920001817AgarPolymers0.000description4
- NLXLAEXVIDQMFP-UHFFFAOYSA-NAmmonia chlorideChemical compound[NH4+].[Cl-]NLXLAEXVIDQMFP-UHFFFAOYSA-N0.000description4
- DCXYFEDJOCDNAF-REOHCLBHSA-NL-asparagineChemical compoundOC(=O)[C@@H](N)CC(N)=ODCXYFEDJOCDNAF-REOHCLBHSA-N0.000description4
- WHUUTDBJXJRKMK-VKHMYHEASA-NL-glutamic acidChemical compoundOC(=O)[C@@H](N)CCC(O)=OWHUUTDBJXJRKMK-VKHMYHEASA-N0.000description4
- TWRXJAOTZQYOKJ-UHFFFAOYSA-LMagnesium chlorideChemical compound[Mg+2].[Cl-].[Cl-]TWRXJAOTZQYOKJ-UHFFFAOYSA-L0.000description4
- QIAFMBKCNZACKA-UHFFFAOYSA-NN-benzoylglycineChemical compoundOC(=O)CNC(=O)C1=CC=CC=C1QIAFMBKCNZACKA-UHFFFAOYSA-N0.000description4
- XSQUKJJJFZCRTK-UHFFFAOYSA-NUreaChemical compoundNC(N)=OXSQUKJJJFZCRTK-UHFFFAOYSA-N0.000description4
- 239000008272agarSubstances0.000description4
- LOKCTEFSRHRXRJ-UHFFFAOYSA-Idipotassium trisodium dihydrogen phosphate hydrogen phosphate dichlorideChemical compoundP(=O)(O)(O)[O-].[K+].P(=O)(O)([O-])[O-].[Na+].[Na+].[Cl-].[K+].[Cl-].[Na+]LOKCTEFSRHRXRJ-UHFFFAOYSA-I0.000description4
- HEBKCHPVOIAQTA-UHFFFAOYSA-Nmeso ribitolNatural productsOCC(O)C(O)C(O)COHEBKCHPVOIAQTA-UHFFFAOYSA-N0.000description4
- 239000002953phosphate buffered salineSubstances0.000description4
- 239000011780sodium chlorideSubstances0.000description4
- 239000000725suspensionSubstances0.000description4
- 229960003487xyloseDrugs0.000description4
- OKTJSMMVPCPJKN-UHFFFAOYSA-NCarbonChemical compound[C]OKTJSMMVPCPJKN-UHFFFAOYSA-N0.000description3
- 108090000790EnzymesProteins0.000description3
- 102000004190EnzymesHuman genes0.000description3
- 240000007228Mangifera indicaSpecies0.000description3
- 235000014826Mangifera indicaNutrition0.000description3
- 229910052799carbonInorganic materials0.000description3
- 239000003153chemical reaction reagentSubstances0.000description3
- 239000000203mixtureSubstances0.000description3
- 238000005067remediationMethods0.000description3
- 235000013311vegetablesNutrition0.000description3
- BJEPYKJPYRNKOW-REOHCLBHSA-N(S)-malic acidChemical compoundOC(=O)[C@@H](O)CC(O)=OBJEPYKJPYRNKOW-REOHCLBHSA-N0.000description2
- OWEGMIWEEQEYGQ-UHFFFAOYSA-N100676-05-9Natural productsOC1C(O)C(O)C(CO)OC1OCC1C(O)C(O)C(O)C(OC2C(OC(O)C(O)C2O)CO)O1OWEGMIWEEQEYGQ-UHFFFAOYSA-N0.000description2
- FJKROLUGYXJWQN-UHFFFAOYSA-N4-hydroxybenzoic acidChemical compoundOC(=O)C1=CC=C(O)C=C1FJKROLUGYXJWQN-UHFFFAOYSA-N0.000description2
- GUBGYTABKSRVRQ-XLOQQCSPSA-NAlpha-LactoseChemical compoundO[C@@H]1[C@@H](O)[C@@H](O)[C@@H](CO)O[C@H]1O[C@@H]1[C@@H](CO)O[C@H](O)[C@H](O)[C@H]1OGUBGYTABKSRVRQ-XLOQQCSPSA-N0.000description2
- 235000004936Bromus mangoNutrition0.000description2
- UXVMQQNJUSDDNG-UHFFFAOYSA-LCalcium chlorideChemical compound[Cl-].[Cl-].[Ca+2]UXVMQQNJUSDDNG-UHFFFAOYSA-L0.000description2
- 240000008067Cucumis sativusSpecies0.000description2
- 235000010799Cucumis sativus var sativusNutrition0.000description2
- GUBGYTABKSRVRQ-CUHNMECISA-ND-CellobioseChemical compoundO[C@@H]1[C@@H](O)[C@H](O)[C@@H](CO)O[C@H]1O[C@@H]1[C@@H](CO)OC(O)[C@H](O)[C@H]1OGUBGYTABKSRVRQ-CUHNMECISA-N0.000description2
- FBPFZTCFMRRESA-FSIIMWSLSA-ND-GlucitolNatural productsOC[C@H](O)[C@H](O)[C@@H](O)[C@H](O)COFBPFZTCFMRRESA-FSIIMWSLSA-N0.000description2
- FBPFZTCFMRRESA-KVTDHHQDSA-ND-MannitolChemical compoundOC[C@@H](O)[C@@H](O)[C@H](O)[C@H](O)COFBPFZTCFMRRESA-KVTDHHQDSA-N0.000description2
- QNAYBMKLOCPYGJ-UHFFFAOYSA-ND-alpha-AlaNatural productsCC([NH3+])C([O-])=OQNAYBMKLOCPYGJ-UHFFFAOYSA-N0.000description2
- HEBKCHPVOIAQTA-QWWZWVQMSA-ND-arabinitolChemical compoundOC[C@@H](O)C(O)[C@H](O)COHEBKCHPVOIAQTA-QWWZWVQMSA-N0.000description2
- FBPFZTCFMRRESA-JGWLITMVSA-ND-glucitolChemical compoundOC[C@H](O)[C@@H](O)[C@H](O)[C@H](O)COFBPFZTCFMRRESA-JGWLITMVSA-N0.000description2
- SHZGCJCMOBCMKK-UHFFFAOYSA-ND-mannomethyloseNatural productsCC1OC(O)C(O)C(O)C1OSHZGCJCMOBCMKK-UHFFFAOYSA-N0.000description2
- WQZGKKKJIJFFOK-QTVWNMPRSA-ND-mannopyranoseChemical compoundOC[C@H]1OC(O)[C@@H](O)[C@@H](O)[C@@H]1OWQZGKKKJIJFFOK-QTVWNMPRSA-N0.000description2
- 108010010803GelatinProteins0.000description2
- WQZGKKKJIJFFOK-GASJEMHNSA-NGlucoseNatural productsOC[C@H]1OC(O)[C@H](O)[C@@H](O)[C@@H]1OWQZGKKKJIJFFOK-GASJEMHNSA-N0.000description2
- SQUHHTBVTRBESD-UHFFFAOYSA-NHexa-Ac-myo-InositolNatural productsCC(=O)OC1C(OC(C)=O)C(OC(C)=O)C(OC(C)=O)C(OC(C)=O)C1OC(C)=OSQUHHTBVTRBESD-UHFFFAOYSA-N0.000description2
- QNAYBMKLOCPYGJ-UWTATZPHSA-NL-AlanineNatural productsC[C@@H](N)C(O)=OQNAYBMKLOCPYGJ-UWTATZPHSA-N0.000description2
- QNAYBMKLOCPYGJ-REOHCLBHSA-NL-alanineChemical compoundC[C@H](N)C(O)=OQNAYBMKLOCPYGJ-REOHCLBHSA-N0.000description2
- ZDXPYRJPNDTMRX-VKHMYHEASA-NL-glutamineChemical compoundOC(=O)[C@@H](N)CCC(N)=OZDXPYRJPNDTMRX-VKHMYHEASA-N0.000description2
- 229930182816L-glutamineNatural products0.000description2
- SHZGCJCMOBCMKK-JFNONXLTSA-NL-rhamnopyranoseChemical compoundC[C@@H]1OC(O)[C@H](O)[C@H](O)[C@H]1OSHZGCJCMOBCMKK-JFNONXLTSA-N0.000description2
- PNNNRSAQSRJVSB-UHFFFAOYSA-NL-rhamnoseNatural productsCC(O)C(O)C(O)C(O)C=OPNNNRSAQSRJVSB-UHFFFAOYSA-N0.000description2
- FEWJPZIEWOKRBE-JCYAYHJZSA-LL-tartrate(2-)Chemical compound[O-]C(=O)[C@H](O)[C@@H](O)C([O-])=OFEWJPZIEWOKRBE-JCYAYHJZSA-L0.000description2
- GUBGYTABKSRVRQ-QKKXKWKRSA-NLactoseNatural productsOC[C@H]1O[C@@H](O[C@H]2[C@H](O)[C@@H](O)C(O)O[C@@H]2CO)[C@H](O)[C@@H](O)[C@H]1OGUBGYTABKSRVRQ-QKKXKWKRSA-N0.000description2
- 239000006142Luria-Bertani AgarSubstances0.000description2
- GUBGYTABKSRVRQ-PICCSMPSSA-NMaltoseNatural productsO[C@@H]1[C@@H](O)[C@H](O)[C@@H](CO)O[C@@H]1O[C@@H]1[C@@H](CO)OC(O)[C@H](O)[C@H]1OGUBGYTABKSRVRQ-PICCSMPSSA-N0.000description2
- 229930195725MannitolNatural products0.000description2
- 241000233647Phytophthora nicotianae var. parasiticaSpecies0.000description2
- 241001135312SinorhizobiumSpecies0.000description2
- 235000009184Spondias indicaNutrition0.000description2
- 229920002472StarchPolymers0.000description2
- CZMRCDWAGMRECN-UGDNZRGBSA-NSucroseChemical compoundO[C@H]1[C@H](O)[C@@H](CO)O[C@@]1(CO)O[C@@H]1[C@H](O)[C@@H](O)[C@H](O)[C@@H](CO)O1CZMRCDWAGMRECN-UGDNZRGBSA-N0.000description2
- 229930006000SucroseNatural products0.000description2
- TVXBFESIOXBWNM-UHFFFAOYSA-NXylitolNatural productsOCCC(O)C(O)C(O)CCOTVXBFESIOXBWNM-UHFFFAOYSA-N0.000description2
- 230000004913activationEffects0.000description2
- 229960003767alanineDrugs0.000description2
- WQZGKKKJIJFFOK-PHYPRBDBSA-Nalpha-D-galactoseChemical compoundOC[C@H]1O[C@H](O)[C@H](O)[C@@H](O)[C@H]1OWQZGKKKJIJFFOK-PHYPRBDBSA-N0.000description2
- BJEPYKJPYRNKOW-UHFFFAOYSA-Nalpha-hydroxysuccinic acidNatural productsOC(=O)C(O)CC(O)=OBJEPYKJPYRNKOW-UHFFFAOYSA-N0.000description2
- 235000019270ammonium chlorideNutrition0.000description2
- PYMYPHUHKUWMLA-WDCZJNDASA-NarabinoseChemical compoundOC[C@@H](O)[C@@H](O)[C@H](O)C=OPYMYPHUHKUWMLA-WDCZJNDASA-N0.000description2
- 229960001230asparagineDrugs0.000description2
- WQZGKKKJIJFFOK-VFUOTHLCSA-Nbeta-D-glucoseChemical compoundOC[C@H]1O[C@@H](O)[C@H](O)[C@@H](O)[C@@H]1OWQZGKKKJIJFFOK-VFUOTHLCSA-N0.000description2
- GUBGYTABKSRVRQ-QUYVBRFLSA-Nbeta-maltoseChemical compoundOC[C@H]1O[C@H](O[C@H]2[C@H](O)[C@@H](O)[C@H](O)O[C@@H]2CO)[C@H](O)[C@@H](O)[C@@H]1OGUBGYTABKSRVRQ-QUYVBRFLSA-N0.000description2
- 239000001110calcium chlorideSubstances0.000description2
- 229910001628calcium chlorideInorganic materials0.000description2
- 239000004202carbamideSubstances0.000description2
- KXGVEGMKQFWNSR-LLQZFEROSA-MdeoxycholateChemical compoundC([C@H]1CC2)[C@H](O)CC[C@]1(C)[C@@H]1[C@@H]2[C@@H]2CC[C@H]([C@@H](CCC([O-])=O)C)[C@@]2(C)[C@@H](O)C1KXGVEGMKQFWNSR-LLQZFEROSA-M0.000description2
- 229940009976deoxycholateDrugs0.000description2
- 238000010586diagramMethods0.000description2
- ZPWVASYFFYYZEW-UHFFFAOYSA-Ldipotassium hydrogen phosphateChemical compound[K+].[K+].OP([O-])([O-])=OZPWVASYFFYYZEW-UHFFFAOYSA-L0.000description2
- 239000012153distilled waterSubstances0.000description2
- 238000001962electrophoresisMethods0.000description2
- 238000005516engineering processMethods0.000description2
- 229930182830galactoseNatural products0.000description2
- 239000008273gelatinSubstances0.000description2
- 229920000159gelatinPolymers0.000description2
- 235000019322gelatineNutrition0.000description2
- 235000011852gelatine dessertsNutrition0.000description2
- 239000008103glucoseSubstances0.000description2
- 229960002989glutamic acidDrugs0.000description2
- 230000009931harmful effectEffects0.000description2
- 239000004009herbicideSubstances0.000description2
- CDAISMWEOUEBRE-GPIVLXJGSA-NinositolChemical compoundO[C@H]1[C@H](O)[C@@H](O)[C@H](O)[C@H](O)[C@@H]1OCDAISMWEOUEBRE-GPIVLXJGSA-N0.000description2
- 229960000367inositolDrugs0.000description2
- -1iron ionChemical class0.000description2
- 239000008101lactoseSubstances0.000description2
- 229910001629magnesium chlorideInorganic materials0.000description2
- 239000001630malic acidSubstances0.000description2
- 235000011090malic acidNutrition0.000description2
- 239000000594mannitolSubstances0.000description2
- 235000010355mannitolNutrition0.000description2
- 238000009629microbiological cultureMethods0.000description2
- 229910000402monopotassium phosphateInorganic materials0.000description2
- 235000019796monopotassium phosphateNutrition0.000description2
- PJNZPQUBCPKICU-UHFFFAOYSA-Nphosphoric acid;potassiumChemical compound[K].OP(O)(O)=OPJNZPQUBCPKICU-UHFFFAOYSA-N0.000description2
- 230000008635plant growthEffects0.000description2
- 125000005575polycyclic aromatic hydrocarbon groupChemical group0.000description2
- 238000000746purificationMethods0.000description2
- BBEAQIROQSPTKN-UHFFFAOYSA-NpyreneChemical compoundC1=CC=C2C=CC3=CC=CC4=CC=C1C2=C43BBEAQIROQSPTKN-UHFFFAOYSA-N0.000description2
- CDAISMWEOUEBRE-UHFFFAOYSA-Nscyllo-inosotolNatural productsOC1C(O)C(O)C(O)C(O)C1OCDAISMWEOUEBRE-UHFFFAOYSA-N0.000description2
- 239000001509sodium citrateSubstances0.000description2
- NLJMYIDDQXHKNR-UHFFFAOYSA-Ksodium citrateChemical compoundO.O.[Na+].[Na+].[Na+].[O-]C(=O)CC(O)(CC([O-])=O)C([O-])=ONLJMYIDDQXHKNR-UHFFFAOYSA-K0.000description2
- 239000000600sorbitolSubstances0.000description2
- 238000005507sprayingMethods0.000description2
- 238000010186stainingMethods0.000description2
- 239000008107starchSubstances0.000description2
- 235000019698starchNutrition0.000description2
- 230000001954sterilising effectEffects0.000description2
- 238000004659sterilization and disinfectionMethods0.000description2
- 239000005720sucroseSubstances0.000description2
- 229940095064tartrateDrugs0.000description2
- 231100000331toxicToxicity0.000description2
- 230000002588toxic effectEffects0.000description2
- 239000000811xylitolSubstances0.000description2
- 235000010447xylitolNutrition0.000description2
- HEBKCHPVOIAQTA-SCDXWVJYSA-NxylitolChemical compoundOC[C@H](O)[C@@H](O)[C@H](O)COHEBKCHPVOIAQTA-SCDXWVJYSA-N0.000description2
- 229960002675xylitolDrugs0.000description2
- HOKKPVIRMVDYPB-UVTDQMKNSA-N(Z)-thiaclopridChemical compoundC1=NC(Cl)=CC=C1CN1C(=N/C#N)/SCC1HOKKPVIRMVDYPB-UVTDQMKNSA-N0.000description1
- RMOGWMIKYWRTKW-UHFFFAOYSA-N1-(4-chlorophenyl)-4,4-dimethyl-2-(1H-1,2,4-triazol-1-yl)pentan-3-olChemical compoundC1=NC=NN1C(C(O)C(C)(C)C)CC1=CC=C(Cl)C=C1RMOGWMIKYWRTKW-UHFFFAOYSA-N0.000description1
- AXDJCCTWPBKUKL-UHFFFAOYSA-N4-[(4-aminophenyl)-(4-imino-3-methylcyclohexa-2,5-dien-1-ylidene)methyl]aniline;hydron;chlorideChemical compoundCl.C1=CC(=N)C(C)=CC1=C(C=1C=CC(N)=CC=1)C1=CC=C(N)C=C1AXDJCCTWPBKUKL-UHFFFAOYSA-N0.000description1
- VTNQPKFIQCLBDU-UHFFFAOYSA-NAcetochlorChemical compoundCCOCN(C(=O)CCl)C1=C(C)C=CC=C1CCVTNQPKFIQCLBDU-UHFFFAOYSA-N0.000description1
- 241000589158AgrobacteriumSpecies0.000description1
- 241000234282AlliumSpecies0.000description1
- 240000006108Allium ampeloprasumSpecies0.000description1
- 235000005254Allium ampeloprasumNutrition0.000description1
- 235000002732Allium cepa var. cepaNutrition0.000description1
- 240000002234Allium sativumSpecies0.000description1
- 241000238557DecapodaSpecies0.000description1
- 208000035240Disease ResistanceDiseases0.000description1
- 229930191978GibberellinNatural products0.000description1
- 241000234280LiliaceaeSpecies0.000description1
- 244000061176Nicotiana tabacumSpecies0.000description1
- 235000002637Nicotiana tabacumNutrition0.000description1
- CBENFWSGALASAD-UHFFFAOYSA-NOzoneChemical compound[O-][O+]=OCBENFWSGALASAD-UHFFFAOYSA-N0.000description1
- 231100000674PhytotoxicityToxicity0.000description1
- 241000589771Ralstonia solanacearumSpecies0.000description1
- 241000589180RhizobiumSpecies0.000description1
- 239000005940ThiaclopridSubstances0.000description1
- 239000005941ThiamethoxamSubstances0.000description1
- 241000696962White spot syndrome virusSpecies0.000description1
- 241000607479Yersinia pestisSpecies0.000description1
- 239000011543agarose gelSubstances0.000description1
- 238000012271agricultural productionMethods0.000description1
- 239000005557antagonistSubstances0.000description1
- 230000003712anti-aging effectEffects0.000description1
- 239000003963antioxidant agentSubstances0.000description1
- 230000003078antioxidant effectEffects0.000description1
- 235000021015bananasNutrition0.000description1
- 230000009286beneficial effectEffects0.000description1
- 238000006065biodegradation reactionMethods0.000description1
- 230000001684chronic effectEffects0.000description1
- 231100000762chronic effectToxicity0.000description1
- 238000011109contaminationMethods0.000description1
- 238000012258culturingMethods0.000description1
- 230000007547defectEffects0.000description1
- 230000007812deficiencyEffects0.000description1
- 230000004069differentiationEffects0.000description1
- 238000007865dilutingMethods0.000description1
- 239000003344environmental pollutantSubstances0.000description1
- 239000004744fabricSubstances0.000description1
- 239000003337fertilizerSubstances0.000description1
- GVEPBJHOBDJJJI-UHFFFAOYSA-NfluoranthreneNatural productsC1=CC(C2=CC=CC=C22)=C3C2=CC=CC3=C1GVEPBJHOBDJJJI-UHFFFAOYSA-N0.000description1
- 235000004611garlicNutrition0.000description1
- IXORZMNAPKEEDV-UHFFFAOYSA-Ngibberellic acid GA3Natural productsOC(=O)C1C2(C3)CC(=C)C3(O)CCC2C2(C=CC3O)C1C3(C)C(=O)O2IXORZMNAPKEEDV-UHFFFAOYSA-N0.000description1
- 239000003448gibberellinSubstances0.000description1
- 239000001963growth mediumSubstances0.000description1
- 230000002363herbicidal effectEffects0.000description1
- 230000006872improvementEffects0.000description1
- 230000005764inhibitory processEffects0.000description1
- 238000011081inoculationMethods0.000description1
- 239000002917insecticideSubstances0.000description1
- XEEYBQQBJWHFJM-UHFFFAOYSA-NironSubstances[Fe]XEEYBQQBJWHFJM-UHFFFAOYSA-N0.000description1
- 229910052742ironInorganic materials0.000description1
- 238000002955isolationMethods0.000description1
- 238000002386leachingMethods0.000description1
- 231100000053low toxicityToxicity0.000description1
- 239000000463materialSubstances0.000description1
- 239000000618nitrogen fertilizerSubstances0.000description1
- 239000002420orchardSubstances0.000description1
- 210000000056organAnatomy0.000description1
- 150000002894organic compoundsChemical class0.000description1
- 230000035699permeabilityEffects0.000description1
- ISWSIDIOOBJBQZ-UHFFFAOYSA-Nphenol groupChemical groupC1(=CC=CC=C1)OISWSIDIOOBJBQZ-UHFFFAOYSA-N0.000description1
- BULVZWIRKLYCBC-UHFFFAOYSA-NphorateChemical compoundCCOP(=S)(OCC)SCSCCBULVZWIRKLYCBC-UHFFFAOYSA-N0.000description1
- 230000000243photosynthetic effectEffects0.000description1
- 231100000719pollutantToxicity0.000description1
- 229920003210poly(4-hydroxy benzoic acid)Polymers0.000description1
- 150000003071polychlorinated biphenylsChemical class0.000description1
- 230000001737promoting effectEffects0.000description1
- 108090000623proteins and genesProteins0.000description1
- 230000008439repair processEffects0.000description1
- 230000001850reproductive effectEffects0.000description1
- 238000012216screeningMethods0.000description1
- 238000000926separation methodMethods0.000description1
- 239000000243solutionSubstances0.000description1
- 238000001179sorption measurementMethods0.000description1
- 241000894007speciesSpecies0.000description1
- 239000007921spraySubstances0.000description1
- 239000008223sterile waterSubstances0.000description1
- 230000004083survival effectEffects0.000description1
- 208000024891symptomDiseases0.000description1
- 239000008399tap waterSubstances0.000description1
- 235000020679tap waterNutrition0.000description1
- NWWZPOKUUAIXIW-FLIBITNWSA-NthiamethoxamChemical compound[O-][N+](=O)\N=C/1N(C)COCN\1CC1=CN=C(Cl)S1NWWZPOKUUAIXIW-FLIBITNWSA-N0.000description1
- 231100000419toxicityToxicity0.000description1
- 230000001988toxicityEffects0.000description1
- 150000003852triazolesChemical class0.000description1
- 230000009105vegetative growthEffects0.000description1
Images
Classifications
- C—CHEMISTRY; METALLURGY
- C12—BIOCHEMISTRY; BEER; SPIRITS; WINE; VINEGAR; MICROBIOLOGY; ENZYMOLOGY; MUTATION OR GENETIC ENGINEERING
- C12N—MICROORGANISMS OR ENZYMES; COMPOSITIONS THEREOF; PROPAGATING, PRESERVING, OR MAINTAINING MICROORGANISMS; MUTATION OR GENETIC ENGINEERING; CULTURE MEDIA
- C12N1/00—Microorganisms, e.g. protozoa; Compositions thereof; Processes of propagating, maintaining or preserving microorganisms or compositions thereof; Processes of preparing or isolating a composition containing a microorganism; Culture media therefor
- C12N1/20—Bacteria; Culture media therefor
- C12N1/205—Bacterial isolates
- C—CHEMISTRY; METALLURGY
- C12—BIOCHEMISTRY; BEER; SPIRITS; WINE; VINEGAR; MICROBIOLOGY; ENZYMOLOGY; MUTATION OR GENETIC ENGINEERING
- C12R—INDEXING SCHEME ASSOCIATED WITH SUBCLASSES C12C - C12Q, RELATING TO MICROORGANISMS
- C12R2001/00—Microorganisms ; Processes using microorganisms
- C12R2001/01—Bacteria or Actinomycetales ; using bacteria or Actinomycetales
- B—PERFORMING OPERATIONS; TRANSPORTING
- B09—DISPOSAL OF SOLID WASTE; RECLAMATION OF CONTAMINATED SOIL
- B09C—RECLAMATION OF CONTAMINATED SOIL
- B09C1/00—Reclamation of contaminated soil
- B09C1/10—Reclamation of contaminated soil microbiologically, biologically or by using enzymes
Landscapes
- Life Sciences & Earth Sciences (AREA)
- Engineering & Computer Science (AREA)
- Health & Medical Sciences (AREA)
- Chemical & Material Sciences (AREA)
- Organic Chemistry (AREA)
- Zoology (AREA)
- Microbiology (AREA)
- Bioinformatics & Cheminformatics (AREA)
- Biotechnology (AREA)
- General Health & Medical Sciences (AREA)
- Genetics & Genomics (AREA)
- Wood Science & Technology (AREA)
- Biochemistry (AREA)
- General Engineering & Computer Science (AREA)
- Biomedical Technology (AREA)
- Medicinal Chemistry (AREA)
- Tropical Medicine & Parasitology (AREA)
- Virology (AREA)
- Molecular Biology (AREA)
- Mycology (AREA)
- Soil Sciences (AREA)
- Environmental & Geological Engineering (AREA)
- Micro-Organisms Or Cultivation Processes Thereof (AREA)
Abstract
Description
Translated fromChinese技术领域technical field
本发明涉及微生物技术及农作物药剂生物降解处理领域,更具体地,涉及一株粘着剑菌Ensifer adhaerensdt8菌株及其在降解多效唑中的应用。The invention relates to the field of microbial technology and biodegradation treatment of crop chemicals, and more particularly, to a strain ofEnsifer adhaerens dt8 and its application in degrading paclobutrazol.
背景技术Background technique
多效唑,分子式为C15H20N3OCl,化学名(2RS,3RS)-1-(4-氯苯基)-4,4-二甲基-2-(1,2,4-三唑-1-基)戊-3-醇,代号PP333,一种人工合成的高效低毒植物生长延缓剂和广谱型杀菌剂有机化合物。多效唑可以控制营养生长,延缓茎的伸长,并使更多光合产物运输到生殖器官,从而达到抑制植物生长、促进花芽分化、提高植物抗倒伏和抗逆性、抑制细菌和害虫,并使植物抗衰老和促产量。然而研究表明,土施多效唑应用与植物时,其在第二年的残留量达到最高,并且危害效用也是在第二年最为明显,在土壤中的残留时间也较长,残效性长达2~3年,对下茬作物生长发育会造成很大影响。除此之外,在土壤中具有较高的吸附率,在田间的淋溶、渗透性较差,影响后茬作物生长。并且喷施浓度、频率过高,也会造成对植物的过分抑制、生长停滞,植株不能恢复正常生长等药害症状,遗留的未分解的多效唑,会造成来年的第二茬蔬菜作物农药残留超标。对多效唑的传统处理方法,既在第二茬作物种植前进行耕翻,亦或是增施氮肥或赤霉素解救;适当增加土壤中有效铁离子浓度和pH以有效降低土壤中的多效唑含量;另一种方法就是改种其他对多效唑具有强抗性的作物,如百合科的大葱、大蒜和韭菜等;而对含有多效唑蔬菜可以用清水或者臭氧水浸泡以达到降低蔬菜中的多效唑含量。除此之外,多效唑对水环境的慢性影响不容忽视,对水生生物具有严重影响,如影响大型蚤的存活率、生长发育和繁殖。因此,降低土壤中的残留农药多效唑含量,降低多效唑在后茬作物中的含量等问题已至关重要。并且目前尚无微生物对三唑类(包括多效唑)农药微生物降解方面的报道。Paclobutrazol, molecular formula is C15 H20 N3 OCl, chemical name (2RS, 3RS)-1-(4-chlorophenyl)-4,4-dimethyl-2-(1,2,4-triazole- 1-yl)pentan-3-ol, codenamed PP333, is a synthetic organic compound of high-efficiency and low-toxicity plant growth retarder and broad-spectrum fungicide. Paclobutrazol can control vegetative growth, delay stem elongation, and transport more photosynthetic products to reproductive organs, thereby inhibiting plant growth, promoting flower bud differentiation, improving plant lodging and stress resistance, inhibiting bacteria and pests, and making plants Anti-aging and boosting yield. However, studies have shown that when soil application of paclobutrazol is applied to plants, its residual amount reaches the highest in the second year, and the harmful effect is also the most obvious in the second year. The residual time in the soil is also longer, and the residual effect is as long as 2~ 3 years, it will have a great impact on the growth and development of the next crop. In addition, it has a high adsorption rate in the soil, and has poor leaching and permeability in the field, which affects the growth of subsequent crops. And the spraying concentration and frequency are too high, it will also cause excessive inhibition of plants, growth stagnation, plants can not return to normal growth and other symptoms of phytotoxicity, the remaining undecomposed paclobutrazol will cause the second crop of vegetable crops in the coming year. . The traditional treatment method for paclobutrazol is to plough before the second crop is planted, or to increase nitrogen fertilizer or gibberellin for rescue; appropriately increase the effective iron ion concentration and pH in the soil to effectively reduce the paclobutrazol content in the soil; Another method is to replant other crops with strong resistance to paclobutrazol, such as onions, garlic and leeks of Liliaceae; and vegetables containing paclobutrazol can be soaked in water or ozone water to reduce the paclobutrazol content in vegetables. In addition, the chronic effects of paclobutrazol on the water environment cannot be ignored, and have serious effects on aquatic organisms, such as affecting the survival rate, growth and reproduction of large fleas. Therefore, it is very important to reduce the content of residual pesticide paclobutrazol in soil and reduce the content of paclobutrazol in subsequent crops. And there is no report on the microbial degradation of triazoles (including paclobutrazol) pesticides.
粘着剑菌(Ensifer adhaerens)与1982年被Casida第一次从土壤中分离得到,并作为一个新属发表;而在后期的研究中,在农杆菌属和根瘤菌属命名委员会上,将剑菌属和中华根瘤菌属合并为一个属,而属中的模式菌株为Sinorhizobium adhaerens,但由于剑菌属较中华根瘤菌属发现较早,因此此合并也未有最终结果。粘着剑菌(Ensifer adhaerens)是一类固氮菌,为革兰氏阴性菌,既可以存活于土壤,也可以定殖于植物体内。可以降解水体中的三致污染物三氯联苯(PCBs);降解难降解的除草剂乙草胺(我国用量三大农药除草剂之一,难降解)、高毒、高残留农药甲拌磷和降解烟碱类杀虫剂噻虫嗪与噻虫啉;降解多环芳烃(PAHs)中的芘,并且降解效果显著。除此之外,粘着剑菌可以降解连坐土壤中的羟基苯甲酸(PHBA),调节黄瓜叶片抗氧化酶,土壤酶活性,以缓解黄瓜连坐障碍;同时研究表明,粘着剑菌有拮抗烟草黑胫病病原菌烟草疫霉,以及拮抗烟草青枯病病原菌青枯罗尔氏菌。另外饲料中添加粘着剑菌后,可以提高虾对白斑综合症病毒的抗病力。Ensifer adhaerens was first isolated from soil by Casida in 1982 and published as a new genus; in a later study, Ensifer adhaerens was named in the nomenclature committee of Agrobacterium and Rhizobium. The genus and Sinorhizobium were merged into one genus, and the type strain in the genus wasSinorhizobium adhaerens . However, the genus was found earlier than Sinorhizobium, so there was no final result of this merger.Ensifer adhaerens is a type of nitrogen-fixing bacteria, gram-negative bacteria, which can survive in soil and colonize plants. It can degrade trichlorobiphenyls (PCBs), the three pollutants in water; degrade the refractory herbicide acetochlor (one of the three major pesticide herbicides in my country, which is refractory to degradation), the highly toxic and high residue pesticide phorate And degradation of nicotinic insecticides thiamethoxam and thiacloprid; degradation of pyrene in polycyclic aromatic hydrocarbons (PAHs), and the degradation effect is remarkable. In addition, S. adherens can degrade the hydroxybenzoic acid (PHBA) in the soil, regulate the activity of antioxidant enzymes and soil enzymes in cucumber leaves, so as to alleviate the cucumber erecting obstacles; at the same time, studies have shown that S. adherens can antagonize tobacco black shank. The pathogen Phytophthora nicotianae, and the antagonist Ralstonia solanacearum. In addition, adding S. adherens to the feed can improve the disease resistance of shrimp to white spot syndrome virus.
但是,目前还未见有可以降解多效唑的粘着剑菌的报道。However, there is no report on S. adherens that can degrade paclobutrazol so far.
发明内容SUMMARY OF THE INVENTION
本发明所要解决的技术问题是克服上述现有技术的缺陷和不足,提供一株可有效降解株粘着剑菌Ensifer adhaerensdt8菌株。The technical problem to be solved by the present invention is to overcome the above-mentioned defects and deficiencies of the prior art, and to provide a strain that can effectively degrade theEnsifer adhaerens dt8 strain.
本发明的第一个目的是提供一株粘着剑菌Ensifer adhaerensdt8菌株。The first object of the present invention is to provide a strain ofEnsifer adhaerens dt8.
本发明的第二个目的是提供所述粘着剑菌Ensifer adhaerensdt8菌株在降解多效唑中的应用。The second object of the present invention is to provide the application of theEnsifer adhaerens dt8 strain in degrading paclobutrazol.
本发明的上述目的是通过以下技术方案给予实现的:The above-mentioned purpose of the present invention is achieved by the following technical solutions:
一株粘着剑菌Ensifer adhaerensdt8菌株,所述菌株于2018年4月3日保藏于广东省微生物菌种保藏中心(GDMCC),菌种保藏号为GDMCC No:60351,分类命名为粘着剑菌(Ensifer adhaerens),保藏地址为广东省广州市先烈中路100号。A strain ofEnsifer adhaerens dt8, which was deposited in the Guangdong Provincial Microbial Culture Collection Center (GDMCC) on April 3, 2018.Ensifer adhaerens ), the deposit address is No. 100, Xianlie Middle Road, Guangzhou City, Guangdong Province.
所述粘着剑菌(Ensifer adhaerens)dt8菌株具有如下形态和生理、生化特性:The dt8 strain ofEnsifer adhaerens has the following morphological, physiological and biochemical properties:
a、菌体形态特性:粘着剑菌(Ensifer adhaerens)dt8菌株呈短杆状。a. Morphological characteristics of cells:Ensifer adhaerens dt8 strain is short rod-shaped.
b、菌落形态特性:在LB琼脂平板上生长速度较快,菌落圆形,呈现乳白色,中间凸起,边缘湿润整齐(30℃,生长24小时),菌落直径1.8-2.0 cm。最适生长温度是30 °C及最佳生长pH值7。b. Morphological characteristics of the colony: the growth rate is faster on the LB agar plate, the colony is round, milky white, with a bulge in the middle, and the edges are moist and neat (30 ℃, growth for 24 hours), and the diameter of the colony is 1.8-2.0 cm. The optimum growth temperature is 30 °C and the optimum growth pH is 7.
c、生理生化特性:兼性好氧,能利用L-谷氨酸、葡萄糖、乳糖、麦芽糖、阿拉伯糖、阿拉伯糖醇木糖、木糖醇、肌醇、酒石酸盐、纤维二糖、马尿酸、尿素、半乳糖、甘露糖、鼠李糖、木糖、甘露糖醇、山梨糖醇、甘油、L-丙氨酸、L-天门冬氨酰胺、L-谷氨酰胺、去氧胆酸盐、柠檬酸钠盐、蔗糖、苹果酸为唯一碳源生长;不能水解明胶和淀粉。菌株耐NaCl的浓度达3.0%。c. Physiological and biochemical properties: facultative aerobic, able to utilize L-glutamic acid, glucose, lactose, maltose, arabinose, arabitol xylose, xylitol, inositol, tartrate, cellobiose, hippuric acid , urea, galactose, mannose, rhamnose, xylose, mannitol, sorbitol, glycerol, L-alanine, L-asparagine, L-glutamine, deoxycholate , sodium citrate, sucrose and malic acid are the only carbon sources for growth; gelatin and starch cannot be hydrolyzed. The strain was resistant to NaCl concentration up to 3.0%.
进一步地,所述Ensifer adhaerensdt8菌株的16S rDNA序列如SEQ ID NO:1所示。Further, the 16S rDNA sequence of theEnsifer adhaerens dt8 strain is shown in SEQ ID NO: 1.
本发明所述粘着剑菌(Ensifer adhaerens)dt8菌株能够在含有多效唑的固体培养基中生长,并且长势较好,其可以分泌胞外酶将培养中的多效唑降解,降低多效唑的含量,解除多效唑对菌体的毒害作用。因此,本发明还请求保护粘着剑菌(Ensiferadhaerens)dt8菌株在耐受多效唑生长和/或降解多效唑中的应用。The dt8 strain ofEnsifer adhaerens of the present invention can grow in a solid medium containing paclobutrazol, and the growth is good, and it can secrete extracellular enzymes to degrade paclobutrazol in culture, reduce the content of paclobutrazol, and relieve the effect of paclobutrazol on paclobutrazol. Toxicity of bacteria. Therefore, the present invention also claims the application ofEnsiferadhaerens dt8 strain in paclobutrazol-tolerant growth and/or degradation of paclobutrazol.
优选地,是在降解土壤中多效唑含量中的应用。Preferably, it is the application in degrading the content of paclobutrazol in soil.
同时,本发明还请求保护所述Ensifer adhaerensdt8菌株在制备降低多效唑含量的菌剂中的应用。At the same time, the present invention also claims to protect the application of theEnsifer adhaerens dt8 strain in the preparation of an inoculum for reducing the content of paclobutrazol.
一种耐受多效唑和/或降解多效唑的菌剂,所述菌剂含有如上所述的Ensiferadhaerensdt8菌株或其发酵液。A paclobutrazol-resistant and/or paclobutrazol-degrading inoculum, the inoculum containing the above-mentionedEnsiferadhaerens dt8 strain or its fermentation broth.
优选地,所述发酵液的OD600为1.5。Preferably, the OD600 of the fermentation broth is 1.5.
优选地,所述菌剂还含有蛭石,发酵液与蛭石的质量体积比为1L:2kg。Preferably, the inoculum further contains vermiculite, and the mass-volume ratio of the fermentation broth to the vermiculite is 1L:2kg.
同时,本发明还请求保护上述菌剂在降解土壤中多效唑含量中的应用。At the same time, the present invention also claims to protect the application of the above bacterial agent in degrading the content of paclobutrazol in soil.
一种降解土壤中多效唑含量的方法,将上述菌剂施用于受多效唑污染的土壤中。A method for degrading the content of paclobutrazol in soil comprises applying the above bacterial agent to soil contaminated with paclobutrazol.
优选地,所述土壤为常年污染的香蕉地或者芒果土壤,所述受污染土壤种植的农作物为香蕉或小麦。Preferably, the soil is a perennial polluted banana field or mango soil, and the crops grown on the polluted soil are bananas or wheat.
与现有技术相比,本发明具有以下有益效果:Compared with the prior art, the present invention has the following beneficial effects:
本发明提供了一株粘着剑菌(Ensifer adhaerens)dt8菌株,该菌株在含多效唑培养基中可以生长,可以降解多效唑以减少其在培养基中的含量,以达到解除多效唑的毒害作用,其可以制备成为微生物肥料或者土壤修复菌株,应用于降解耕作土壤中多效唑,解除多效唑对作物或其他植物抑制顶端生长的胁迫作用,以及降低作物携带多效唑进入食物链的可能性,可广泛应用于农业生产和土壤修复及改良等方面,具有较大的应用前景。The invention provides a dt8 strain ofEnsifer adhaerens , which can grow in a medium containing paclobutrazol, can degrade paclobutrazol to reduce its content in the medium, so as to relieve the toxic effect of paclobutrazol, and can It can be prepared as microbial fertilizer or soil remediation strain, which can be used to degrade paclobutrazol in cultivated soil, relieve the stress effect of paclobutrazol on crops or other plants to inhibit the growth of the top, and reduce the possibility of crops carrying paclobutrazol into the food chain, which can be widely used in agricultural production and soil It has great application prospects in terms of repair and improvement.
附图说明Description of drawings
图1为菌株dt8稀释后涂布于LB固体培养基上培养24小时后菌落图。Figure 1 is a colony diagram of the strain dt8 after being diluted and spread on LB solid medium for 24 hours.
图2为菌株16S rDNA PCR产物电泳图。Fig. 2 is the electrophoresis image of the 16S rDNA PCR product of the strain.
图3为菌株dt8稀释后涂布于多效唑无机盐固体培养基上培养24小时后菌落图。Figure 3 is a colony diagram of the strain dt8 after being diluted and spread on paclobutrazol inorganic salt solid medium for 24 hours.
图4为菌株dt8施用香蕉苗葡效果图,左边为喷清水对照,右边为施用dt8菌株。Figure 4 shows the effect of applying the strain dt8 to banana seedlings, the left side is the water spray control, and the right side is the application of the dt8 strain.
图5为菌株dt8对多效唑污染土壤的修复效果测试图,左边为喷清水对照,右边为施用dt8菌株。Figure 5 is a test chart of the remediation effect of strain dt8 on paclobutrazol-contaminated soil. The left side is the control of spraying water, and the right side is the application of dt8 strain.
具体实施方式Detailed ways
以下结合说明书附图和具体实施例来进一步说明本发明,但实施例并不对本发明做任何形式的限定。除非特别说明,本发明采用的试剂、方法和设备为本技术领域常规试剂、方法和设备。The present invention is further described below with reference to the accompanying drawings and specific embodiments, but the embodiments do not limit the present invention in any form. Unless otherwise specified, the reagents, methods and equipment used in the present invention are conventional reagents, methods and equipment in the technical field.
除非特别说明,以下实施例所用试剂和材料均为市购。Unless otherwise specified, the reagents and materials used in the following examples are commercially available.
实施例1 菌株的分离、纯化及筛选Example 1 Isolation, purification and screening of strains
发明人从海南省澄迈县福山镇香蕉园土壤中分离纯化得到耐受农药多效唑的微生物,具体分离纯化步骤如下:其中多效唑无机盐培养基为:氯化钠1g,氯化镁0.2g,氯化铵0.5g,氯化钙0.02g,磷酸氢二钾0.5g,磷酸二氢钾0.5g,蒸馏水1000mL,PH自然(6.5),固体加琼脂粉18g/L,121℃灭菌20分钟,灭菌后加15%多效唑粉末1g。The inventor isolated and purified microorganisms resistant to the pesticide paclobutrazol from the soil of banana gardens in Fushan Town, Chengmai County, Hainan Province. The specific separation and purification steps were as follows: wherein the paclobutrazol inorganic salt medium was: 1 g of sodium chloride, 0.2 g of magnesium chloride, ammonium chloride 0.5g, calcium chloride 0.02g, dipotassium hydrogen phosphate 0.5g, potassium dihydrogen phosphate 0.5g, distilled water 1000mL, PH natural (6.5), solid plus agar powder 18g/L, sterilized at 121 ℃ for 20 minutes, after sterilization Add 1g of 15% paclobutrazol powder.
将从海南省澄迈县福山镇香蕉园中采取回来的土样用灭过菌的碾砵碾碎,称取10g土样用90mL磷酸缓冲液(PBS)震荡悬浮10分钟,取100µL菌液涂布平板,28度培养箱培养。而用液体培养基培养时,利用液体培养基(不加琼脂粉),吸取100μL菌液28度摇床培养7天,待培养液很浑浊吸5μL涂平板分离纯化。观察菌体的生长情况,用接种环挑取长势较好并不同形态特征的菌苔,用平板划线法进行反复传代培养,直至菌落的颜色、形状、大小、质地和透明度一样。最后通过简单染色(石碳酸复红染色)和显微镜镜检(油镜),进一步观察其形态,以长度均一、宽度一致、染色情况统一为菌株纯化标准。将纯化后的dt8菌株于15%的甘油中-20℃和-80℃保存。The soil samples collected from the banana orchard in Fushan Town, Chengmai County, Hainan Province were crushed with a sterilized grinder, and 10 g of soil samples were weighed and suspended in 90 mL of phosphate buffered saline (PBS) for 10 minutes. Cloth plate, 28 degrees incubator culture. When culturing with liquid medium, use liquid medium (without adding agar powder), suck 100 μL of bacterial liquid for 7 days on a shaker at 28 degrees, and when the culture medium is very turbid, suck 5 μL and spread it on a plate to separate and purify. The growth of the bacteria was observed, and the bacterial lawns with good growth and different morphological characteristics were picked with the inoculation loop, and subcultured repeatedly by the plate streaking method until the color, shape, size, texture and transparency of the colonies were the same. Finally, the morphology was further observed by simple staining (phenolic fuchsin staining) and microscopic examination (oil microscope). The purified dt8 strain was stored at -20°C and -80°C in 15% glycerol.
实施例2 菌株的生理生化特性及分类地位Example 2 Physiological and biochemical characteristics and taxonomic status of strains
菌株的鉴定及保藏:实施例1分离得到的dt8菌株具有如下形态和生理、生化特性:Identification and preservation of strains: The dt8 strain isolated in Example 1 has the following morphological, physiological and biochemical properties:
a、菌体形态特性:所述菌株呈短杆状。a. Morphological characteristics of the cells: the strains are short rod-shaped.
b、菌落形态特性:在LB琼脂平板上生长速度较快,菌落圆形,呈现乳白色,中间凸起,边缘湿润整齐(30℃,生长24小时),菌落直径1.8-2.0 cm。最适生长温度是30 °C及最佳生长pH值7。b. Morphological characteristics of the colony: the growth rate is faster on the LB agar plate, the colony is round, milky white, with a bulge in the middle, and the edges are moist and neat (30 ℃, growth for 24 hours), and the diameter of the colony is 1.8-2.0 cm. The optimum growth temperature is 30 °C and the optimum growth pH is 7.
c、生理生化特性:兼性好氧,能利用L-谷氨酸、葡萄糖、乳糖、麦芽糖、阿拉伯糖、阿拉伯糖醇木糖、木糖醇、肌醇、酒石酸盐、纤维二糖、马尿酸、尿素、半乳糖、甘露糖、鼠李糖、木糖、甘露糖醇、山梨糖醇、甘油、L-丙氨酸、L-天门冬氨酰胺、L-谷氨酰胺、去氧胆酸盐、柠檬酸钠盐、蔗糖、苹果酸为唯一碳源生长;不能水解明胶和淀粉。菌株耐NaCl的浓度达3.0%。c. Physiological and biochemical properties: facultative aerobic, able to utilize L-glutamic acid, glucose, lactose, maltose, arabinose, arabitol xylose, xylitol, inositol, tartrate, cellobiose, hippuric acid , urea, galactose, mannose, rhamnose, xylose, mannitol, sorbitol, glycerol, L-alanine, L-asparagine, L-glutamine, deoxycholate , sodium citrate, sucrose and malic acid are the only carbon sources for growth; gelatin and starch cannot be hydrolyzed. The strain was resistant to NaCl concentration up to 3.0%.
d、分子分类地位的确定d. Determination of molecular classification status
提取实施例1分离得到的dt8菌株的DNA,扩增16S rDNA基因,并琼脂糖凝胶检测,其扩增产物点电泳图如图2所示;将PCR扩增产物交由广州擎科生物技术有限公司直接进行测序,获得菌株的16S rDNA序列(如SEQ ID NO:1所示),将16S rDNA序列输入GenBank进行Blast比对,初步确定本发明的dt8菌株在分类学中的属、种的位置。结果发现本发明的dt8菌株,与粘着剑菌(Ensifer adhaerens)模式菌株ATCC 33212相似性为99.86%。因此将本发明的dt8菌株应归属于粘着剑菌(Ensifer adhaerens)。Extract the DNA of the dt8 strain isolated in Example 1, amplify the 16S rDNA gene, and detect it on agarose gel. The spot electropherogram of the amplified product is shown in Figure 2; the PCR amplified product was handed over to Guangzhou Qingke Biotechnology Co., Ltd. directly sequenced, obtained the 16S rDNA sequence of the strain (as shown in SEQ ID NO: 1), imported the 16S rDNA sequence into GenBank for Blast comparison, and preliminarily determined the genus and species of the dt8 strain of the present invention in the taxonomy Location. As a result, it was found that the dt8 strain of the present invention was 99.86% similar to the type strain ATCC 33212 ofEnsifer adhaerens . Therefore, the dt8 strain of the present invention should be attributed toEnsifer adhaerens .
本发明所述的粘着剑菌(Ensifer adhaerens)dt8已于2018年4月3日保藏于广东省微生物菌种保藏中心(GDMCC),菌种保藏号为GDMCC No:60351,分类命名为粘着剑菌(Ensifer adhaerens),保藏地址为广东省广州市先烈中路100号。TheEnsifer adhaerens dt8 of the present invention has been deposited in the Guangdong Provincial Microbial Culture Collection Center (GDMCC) on April 3, 2018, and the strain preservation number is GDMCC No: 60351, and the classification name is Ensifer adhaerens. (Ensifer adhaerens ), the deposit address is No. 100, Xianlie Middle Road, Guangzhou City, Guangdong Province.
实施例3Example 3
多效唑无机盐培养基:氯化钠 1g,氯化镁 0.2g,氯化铵 0.5g,氯化钙 0.02g,磷酸氢二钾 0.5g,磷酸二氢钾 0.5g,蒸馏水定容至1L,pH 自然(6.5),琼脂粉18g,121℃灭菌20分钟,灭菌后加15%多效唑粉末1 g。Paclobutrazol inorganic salt medium: sodium chloride 1g, magnesium chloride 0.2g, ammonium chloride 0.5g, calcium chloride 0.02g, dipotassium hydrogen phosphate 0.5g, potassium dihydrogen phosphate 0.5g, distilled water to 1L, pH natural ( 6.5), 18 g of agar powder, sterilized at 121 °C for 20 minutes, and then added 1 g of 15% paclobutrazol powder after sterilization.
将分离纯化的粘着剑菌(Ensifer adhaerens)dt8菌株活化后,制成菌悬液,OD600=0.2;稀释10-2后,涂布于灭菌的多效唑无机盐培养基上,37℃培养24~36小时。The isolated and purified dt8 strain ofEnsifer adhaerens was activated to prepare a bacterial suspension with OD600 = 0.2; after diluting 10-2 , it was spread on sterilized paclobutrazol inorganic salt medium and cultured at 37°C for 24 ~36 hours.
结果如图3所示,菌株dt8稀释后涂布于多效唑无机盐固体培养基上培养24小时后,菌株能够利用多效唑作为碳源生长。The results are shown in Figure 3. After the strain dt8 was diluted and spread on the paclobutrazol inorganic salt solid medium and cultivated for 24 hours, the strain could use paclobutrazol as a carbon source for growth.
实施例4Example 4
将粘着剑菌(E. adhaerens)dt8配制为OD=0.5的菌悬液,以1%的接种量,接种到含100mL多效唑无机盐液体培养基(配方见实施例3,不加琼脂)的500mL体积的三角瓶中培养,以80 rpm摇瓶培养,三个重复,3天后,平均有67.2±1%的多效唑被降解;5天后,平均有85.3±0.6%的多效唑被降解;7天后,平均有93.5±0.7%的多效唑被降解。Adhaerens (E. adhaerens ) dt8 was prepared as a bacterial suspension of OD=0.5, and inoculated into 500 mL of a liquid medium containing 100 mL of paclobutrazol inorganic salt liquid medium (see Example 3 for the recipe, without adding agar) at an inoculum of 1%. Three replicates of three replicates were cultured in three volumes of Erlenmeyer flasks at 80 rpm. After 3 days, an average of 67.2 ± 1% of paclobutrazol was degraded; after 5 days, an average of 85.3 ± 0.6% of paclobutrazol was degraded; after 7 days, an average of 93.5±0.7% of paclobutrazol was degraded.
实施例5Example 5
挑取活化得到的粘着剑菌(Ensifer adhaerens)dt8单菌落于灭菌PBS中震荡混匀,接种于液体LB培养基中,30℃培养36~48小时,致使菌体浓度OD600达到1.5。用蛭石作载体,将粘着剑菌发酵液与蛭石(1:2)混合(如1升培养液混合2公斤蛭石),制备成菌数达1.5~2.0´109 CFU.g-1的菌剂。Pick the single colony ofEnsifer adhaerens dt8 obtained by activation, shake and mix in sterilized PBS, inoculate it in liquid LB medium, and cultivate at 30°C for 36 to 48 hours, so that the OD600 of the cell concentration reaches 1.5. Using vermiculite as a carrier, mix the fermentation broth of S. adherens with vermiculite (1:2) (for example, 1 liter of broth is mixed with 2 kg of vermiculite), and the number of bacteria is 1.5~2.0´109 CFU.g-1 's fungicide.
将粘着剑菌-蛭石接种剂0.5kg施用于海南地区受多效唑污染的香蕉苗葡,另外,以不施用菌剂的香蕉苗圃作为对照,种植香蕉苗,待其长大。0.5kg of S. adherensis-vermiculite inoculant was applied to the banana seedlings polluted by paclobutrazol in Hainan area, and in addition, the banana seedlings without the use of inoculants were used as a control to plant banana seedlings and wait for them to grow up.
结果如图4所示,与对照相比,施用菌剂dt8后,香蕉苗茎秆恢复正常生长,而对照香蕉茎秆变矮,表明粘着剑菌(Ensifer adhaerens)dt8菌株可有效降解受多效唑污染的土壤中的多效唑,促进作物的生长。The results are shown in Figure 4. Compared with the control, the stems of banana seedlings returned to normal growth after the application of the inoculant dt8, while the control banana stems became shorter, indicating that the dt8 strain ofEnsifer adhaerens could effectively degrade the paclobutrazol contamination. paclobutrazol in the soil to promote crop growth.
实施例6Example 6
海南芒果区受控梢控花技术的限制,多年使用大量的多效唑,而多效唑难被土壤微生物降解,因此常年富集,不仅容易抑制芒果树及其他作物的生长,更容易破坏土壤生态。选取海南芒果园区多效唑污染较重的园区土壤为测试对象,对比多效唑降解菌dt8对该土壤的修复效果。The Hainan mango area is limited by the controlled shoot and flower control technology, and a large amount of paclobutrazol has been used for many years. However, paclobutrazol is difficult to be degraded by soil microorganisms, so it is enriched all year round, which not only easily inhibits the growth of mango trees and other crops, but also damages the soil ecology. The soil of Hainan Mango Park with heavy paclobutrazol pollution was selected as the test object, and the remediation effect of paclobutrazol-degrading bacteria dt8 on the soil was compared.
挑取活化得到的粘着剑菌(Ensifer adhaerens)dt8单菌单菌落于灭菌PBS中震荡混匀,后涂布于固体培养基平板上,30℃培养36~48小时。待平板上长满菌体,收集菌体于无菌水中,稀释菌体浓度制备菌悬液OD600为1.0。将从海南芒果园区多效唑污染较重的园区采到的供试土壤装入一次性塑料杯中,种植小麦(共十杯,试验组和对照组各5杯),待小麦出芽后淋施菌悬液一次,而对照则淋施自来水,一个月后观察小麦幼苗长势;Pick the single colony ofEnsifer adhaerens dt8 obtained by activation, shake and mix in sterilized PBS, then spread it on a solid medium plate, and cultivate at 30°C for 36-48 hours. When the plate is covered with bacterial cells, collect the bacterial cells in sterile water, and dilute the bacterial concentration to prepare a bacterial suspension with an OD600 of 1.0. The test soil collected from the paclobutrazol-contaminated park in Hainan Mango Park was put into disposable plastic cups, and wheat (10 cups in total, 5 cups in the test group and 5 cups in the control group) were planted. The control was sprayed with tap water once, and the growth of the wheat seedlings was observed after one month;
结果如图5所示,结果表明粘着剑菌(Ensifer adhaerens)dt8菌株具有降低土壤中多效唑含量能力,施用了多效唑菌悬液处理的小麦幼苗长势较对照好,并且也较对照更绿更高,从而减轻了多效唑对小麦的危害作用。The results are shown in Figure 5. The results show that theEnsifer adhaerens dt8 strain has the ability to reduce the content of paclobutrazol in the soil. The wheat seedlings treated with the paclobutrazol suspension are better than the control, and are also greener and taller than the control. Thus, the harmful effect of paclobutrazol on wheat is reduced.
序列表 sequence listing
<110> 华南农业大学<110> South China Agricultural University
<120> 一株粘着剑菌dt8菌株及其在降解多效唑中的应用<120> A strain of S. adherens dt8 and its application in degrading paclobutrazol
<130> YG18103569AX037<130> YG18103569AX037
<141> 2018-05-08<141> 2018-05-08
<160> 1<160> 1
<170> SIPOSequenceListing 1.0<170> SIPOSequenceListing 1.0
<210> 1<210> 1
<211> 1465<211> 1465
<212> DNA<212> DNA
<213> 粘着剑菌dt8(Ensifer adhaerens dt8)<213> Ensifer adhaerens dt8
<400> 1<400> 1
cgaaccctgg cggcaggctt acacatgcaa gtcgagcgcc ccgcaagggg agcggcagac 60cgaaccctgg cggcaggctt acacatgcaa gtcgagcgcc ccgcaagggg agcggcagac 60
gggtgagtaa cgcgtgggaa tctacccttt tctacggaat aacgcaggga aacttgtgct 120gggtgagtaa cgcgtgggaa tctacccttt tctacggaat aacgcaggga aacttgtgct 120
aataccgtat acgcccttcg ggggaaagat ttatcgggaa aggatgagcc cgcgttggat 180aataccgtat acgcccttcg ggggaaagat ttatcgggaa aggatgagcc cgcgttggat 180
tagctagttg gtggggtaaa ggcctaccaa ggcgacgatc catagctggt ctgagaggat 240tagctagttg gtggggtaaa ggcctaccaa ggcgacgatc catagctggt ctgagaggat 240
gatcagccac attgggactg agacacggcc caaactccta cgggaggcag cagtggggaa 300gatcagccac attgggactg agacacggcc caaactccta cgggaggcag cagtggggaa 300
tattggacaa tgggcgcaag cctgatccag ccatgccgcg tgagtgatga aggccctagg 360tattggacaa tgggcgcaag cctgatccag ccatgccgcg tgagtgatga aggccctagg 360
gttgtaaagc tctttcaccg gtgaagataa tgacggtaac cggagaagaa gccccggcta 420gttgtaaagc tctttcaccg gtgaagataa tgacggtaac cggagaagaa gccccggcta 420
acttcgtgcc agcagccgcg gtaatacgaa gggggctagc gttgttcgga attactgggc 480acttcgtgcc agcagccgcg gtaatacgaa gggggctagc gttgttcgga attactgggc 480
gtaaagcgca cgtaggcgga catttaagtc aggggtgaaa tcccggggct caaccccgga 540gtaaagcgca cgtaggcgga catttaagtc aggggtgaaa tcccggggct caaccccgga 540
actgcctttg atactgggtg tctagagtat ggaagaggtg agtggaattc cgagtgtaga 600actgcctttg atactgggtg tctagagtat ggaagaggtg agtggaattc cgagtgtaga 600
ggtgaaattc gtagatattc ggaggaacac cagtggcgaa ggcggctcac tggtccatta 660ggtgaaattc gtagatattc ggaggaacac cagtggcgaa ggcggctcac tggtccatta 660
ctgacgctga ggtgcgaaag cgtggggagc aaacaggatt agataccctg gtagtccacg 720ctgacgctga ggtgcgaaag cgtggggagc aaacaggatt agataccctg gtagtccacg 720
ccgtaaacga tgaatgttag ccgtcgggca gtttactgtt cggtggcgca gctaacgcat 780ccgtaaacga tgaatgttag ccgtcgggca gtttactgtt cggtggcgca gctaacgcat 780
taaacattcc gcctggggag tacggtcgca agattaaaac tcaaaggaat tgacgggggc 840taaacattcc gcctggggag tacggtcgca agattaaaac tcaaaggaat tgacgggggc 840
ccgcacaagc ggtggagcat gtggtttaat tcgaagcaac gcgcagaacc ttaccagccc 900ccgcacaagc ggtggagcat gtggtttaat tcgaagcaac gcgcagaacc ttaccagccc 900
ttgacatccc gatcgcggat tacggagacg ttttccttca gttcggctgg atcggagaca 960ttgacatccc gatcgcggat tacggagacg ttttccttca gttcggctgg atcggagaca 960
ggtgctgcat ggctgtcgtc agctcgtgtc gtgagatgtt gggttaagtc ccgcacgagc 1020ggtgctgcat ggctgtcgtc agctcgtgtc gtgagatgtt gggttaagtc ccgcacgagc 1020
gcaaccctcg cccttagttg ccagcattta gttgggcacc tctaagggga ctgccggtga 1080gcaaccctcg cccttagttg ccagcattta gttgggcacc tctaagggga ctgccggtga 1080
taagccgaga ggaaggtggg gatgacgtca agtcctcatg gcccttacgg gctgggctac 1140taagccgaga ggaaggtggg gatgacgtca agtcctcatg gcccttacgg gctgggctac 1140
taagccgaga ggaaggtggg gatgacgtca agtcctcatg gcccttacgg gctgggctac 1200taagccgaga ggaaggtggg gatgacgtca agtcctcatg gcccttacgg gctgggctac 1200
acacgtgcta caatggtggt gacagtgggc agcgagaccg cgaggtcgag ctaatctcca 1260acacgtgcta caatggtggt gacagtgggc agcgagaccg cgaggtcgag ctaatctcca 1260
aaagccatct cagttcggat tgcactctgc aactcgagtg catgaagttg gaatcgctag 1320aaagccatct cagttcggat tgcactctgc aactcgagtg catgaagttg gaatcgctag 1320
taatcgcaga tcagcatgct gcggtgaata cgttcccggg ccttgtacac accgcccgtc 1380taatcgcaga tcagcatgct gcggtgaata cgttcccggg ccttgtacac accgcccgtc 1380
acaccatggg agttggttct acccgaaggt agtgcgctaa ccgcaaggag gcagctaacc 1440acaccatggg agttggttct acccgaaggt agtgcgctaa ccgcaaggag gcagctaacc 1440
acggtagggt cagcgactgg ggtgc 1465acggtagggt cagcgactgg ggtgc 1465
Claims (9)
Priority Applications (1)
| Application Number | Priority Date | Filing Date | Title |
|---|---|---|---|
| CN201810434289.6ACN108728374B (en) | 2018-05-08 | 2018-05-08 | A strain of S. adherens dt8 and its application in degrading paclobutrazol |
Applications Claiming Priority (1)
| Application Number | Priority Date | Filing Date | Title |
|---|---|---|---|
| CN201810434289.6ACN108728374B (en) | 2018-05-08 | 2018-05-08 | A strain of S. adherens dt8 and its application in degrading paclobutrazol |
Publications (2)
| Publication Number | Publication Date |
|---|---|
| CN108728374A CN108728374A (en) | 2018-11-02 |
| CN108728374Btrue CN108728374B (en) | 2020-10-23 |
Family
ID=63937268
Family Applications (1)
| Application Number | Title | Priority Date | Filing Date |
|---|---|---|---|
| CN201810434289.6AActiveCN108728374B (en) | 2018-05-08 | 2018-05-08 | A strain of S. adherens dt8 and its application in degrading paclobutrazol |
Country Status (1)
| Country | Link |
|---|---|
| CN (1) | CN108728374B (en) |
Families Citing this family (5)
| Publication number | Priority date | Publication date | Assignee | Title |
|---|---|---|---|---|
| CN113214534B (en)* | 2021-02-11 | 2022-12-09 | 浙江理工大学 | Method for recycling and biologically utilizing polypropylene flame-retardant plastic |
| CN114317637B (en)* | 2021-12-29 | 2023-02-07 | 苏州科宁多元醇有限公司 | Preparation method and application of polygonatum sibiricum oligosaccharide |
| CN114292797B (en)* | 2022-03-08 | 2022-05-24 | 佛山市玉凰生态环境科技有限公司 | Physarum viscosum and application of microbial flocculant thereof in sewage treatment |
| CN116904349B (en)* | 2023-06-15 | 2024-03-22 | 中国科学院上海高等研究院 | A kind of adherent sword fungus with aerobic denitrification ability and its application |
| CN118165895B (en)* | 2024-05-11 | 2024-07-05 | 木源生物科技(海南)有限公司 | Alternaria alternata B1-9 and application thereof |
Family Cites Families (2)
| Publication number | Priority date | Publication date | Assignee | Title |
|---|---|---|---|---|
| CN102851237B (en)* | 2012-08-07 | 2014-03-26 | 南京师范大学 | Ensiferadhaerens and application thereof |
| US20200245627A1 (en)* | 2016-01-19 | 2020-08-06 | Bioconsortia, Inc. | Agriculturally beneficial microbes, microbial compositions, and consortia |
- 2018
- 2018-05-08CNCN201810434289.6Apatent/CN108728374B/enactiveActive
Also Published As
| Publication number | Publication date |
|---|---|
| CN108728374A (en) | 2018-11-02 |
Similar Documents
| Publication | Publication Date | Title |
|---|---|---|
| CN110257290B (en) | Plant pathogenic bacteria inhibitor, and strain and application thereof | |
| CN108728374B (en) | A strain of S. adherens dt8 and its application in degrading paclobutrazol | |
| CN104164394B (en) | The bacterial strain of one strain antagonistic phytopathogen and application thereof | |
| CN114854618B (en) | A strain of Bacillus Velezii SF327 and its application | |
| CN102965314B (en) | Preparation and application of a strain of Bacillus subtilis and its bacterial agent | |
| CN110452832B (en) | An acid-resistant Bacillus amyloliquefaciens Kc-5 and its application | |
| CN113005056A (en) | Bacillus belgii HY19 and application thereof | |
| CN106995791A (en) | A kind of bacillus subtilis BS193 for preventing and treating the late blight of potato and its application | |
| CN111187741B (en) | Biocontrol pseudomonas and application thereof | |
| CN107136122B (en) | A kind of biocontrol agent for preventing and controlling potato late blight | |
| CN104651260A (en) | Brevibacillus brevis BBC-3 and application thereof as well as preparation method of microbial inoculum of brevibacillus brevis | |
| KR20080045346A (en) | Novel Bacillus subtilis M27 strain and method for controlling plant fungal disease comprising the active ingredient | |
| CN110317747A (en) | A kind of bacillus amyloliquefaciens JT68 and its application in prevention and treatment tea anthracnose | |
| CN103382449B (en) | Streptomyces sp. T2-10 with broad-spectrum insecticidal and antibacterial activity and its application | |
| Türkölmez et al. | Clonostachys rosea Strain ST1140: An Endophytic Plant-Growth-Promoting Fungus, and Its Potential Use in Seedbeds with Wheat-Grain Substrate: Ş. Türkölmez et al. | |
| CN102994419A (en) | Bacillus pumilus LNXM12 and application thereof | |
| CN102978130B (en) | Bacillus pumilus GBSC66 and its application | |
| KR101535893B1 (en) | New microorganism Bacillus amyloliquefaciens CC110 and Microbial agent biopesticide containing the same | |
| CN105112325A (en) | Bacillus cereus bacterial strain WL08 for efficiently degrading dimethomorph, and application and using method of bacillus cereus bacterial strain | |
| CN118028140A (en) | Bacillus amyloliquefaciens SF883 and application thereof | |
| CN118028141A (en) | Bacillus bailii SF4 and application thereof | |
| CN108998395A (en) | A kind of bacillus amyloliquefaciens and application thereof | |
| CN116716225A (en) | Streptomyces radiodurans and its application | |
| CN111349589B (en) | Bacillus amyloliquefaciens for preventing and treating stem rot of anoectochilus roxburghii and application thereof | |
| CN110438026B (en) | Bacillus amyloliquefaciens GLD-191 and microbial inoculum, preparation method and application thereof |
Legal Events
| Date | Code | Title | Description |
|---|---|---|---|
| PB01 | Publication | ||
| PB01 | Publication | ||
| SE01 | Entry into force of request for substantive examination | ||
| SE01 | Entry into force of request for substantive examination | ||
| GR01 | Patent grant | ||
| GR01 | Patent grant |